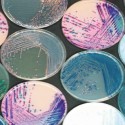

Suppliers of Quality Laboratory Equipment in Kenya
29 Mar, 2017 9:35 AM
Any laboratory test is supposed to be accurate if it's to be relied upon. For this to be possible, quality and updated lab equipment are needed for the test. And that's where we come in.
For years, we have been supplying the best laboratory equipment such as lab instruments, quality control equipment, culture media, milk and dairy testing equipment, chemical and glassware.
Our quality control equipment is a complete in-house machine that helps keep a strict quality control parameter and ensure consistently high-quality products made in the laboratory. Our instrument is exceptionally good looking and comes with easy to understand user instruction manual books.
To get in touch with us, call +254 733 907 902 or visit us at 9Kirinyaga Rd Nairobi.